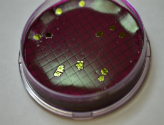

Laboratory Services
GCT utilizes the latest technology to ensure our clients receive highly accurate and definsible data. We routinely analyze samples for compliance to the EPA, ODEQ, Department of Mines, various Native American tribes, and other regulatory authorities. We use method sources from the EPA, Standard Methods, ODEQ, ASTM and other sources as required.

Analytical Testing
GCT conducts a wide range of testing including metals by ICP, ICP/MS, and Cold Vapor, organics by GC and GC/MS, and a multitude of other wet chemical techniques.
Microbiological
We routinely analyze samples for Enterococci, Total and Fecal Coliform, and E. coli. by EPA approved methods including membrane filtration and IDEXX.

Sampling Services
GCT offers a wide range of sampling services that correlate to our testing capabilities. We service Northeastern Oklahoma and maintain a route.
Did You Know?

Periodically the EPA updates the requirements and methods. The most recent large scale change was the 2012 Method Update Rule (MUR). If you’re testing for NPDES compliance (city permits fall into this category), the test procedures used must be consistent with the MUR. In February, 2015, the EPA proposed a new MUR for comments, but it has not been promulgated.
2012 MUR.
http://www.gpo.gov/fdsys/pkg/FR-2012-05-18/pdf/2012-10210.pdf
Proposed 2015 MUR
http://www.gpo.gov/fdsys/pkg/FR-2015-02-19/pdf/2015-02841.pdf
